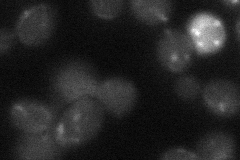
YMR313C

View description
Bifunctional enzyme with triacylglycerol lipase and lysophosphatidylethanolamine acyltransferase activity; responsible for all the triacylglycerol lipase activity of the lipid particle; required with Tgl4p for timely bud formation
Localization:
Intensity:
Fold change:
Significance:
-
C’ GFP library in SD

punctate30.36 -
N' NOP1pr-GFP in SD

punctate42.9221 -
N' TEF2pr-mCherry in SD

punctate48.6603 -
N' NATIVEpr-GFP in SD

punctate26.0711 -
N' TEF2pr-VC and Cyto-VN in SD
punctate27.7711 -
C’ GFP library in SD+DTT

punctate37.411.23No -
C’ GFP library in SD+H2O2

punctate36.361.19No -
C’ GFP library in Starvation Media

punctate48.711.6Yes -
C’ GFP library on the background of Pup2-DaMP

punctate -
C’ GFP library on the background of CCT mutant

punctate30.34490.999172No
